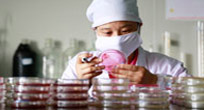

-
 笔迹鉴定;指纹鉴定;文书形成时间;印章印文鉴定;签名鉴定;污损文件鉴定;篡改文件鉴定;朱墨时序鉴定;打印、传真、印刷文书材料、票证真伪鉴定
笔迹鉴定;指纹鉴定;文书形成时间;印章印文鉴定;签名鉴定;污损文件鉴定;篡改文件鉴定;朱墨时序鉴定;打印、传真、印刷文书材料、票证真伪鉴定 -
 指纹手印、足迹鉴定、鞋印鉴定、脚印鉴定、枪弹痕迹鉴定、物体破裂痕迹鉴定、工具痕迹、整体分离痕迹 交通事故鉴定(含现场勘查)
指纹手印、足迹鉴定、鞋印鉴定、脚印鉴定、枪弹痕迹鉴定、物体破裂痕迹鉴定、工具痕迹、整体分离痕迹 交通事故鉴定(含现场勘查) -
 酒精测试、毒物毒性、中毒机理 代谢功能、定量分析
酒精测试、毒物毒性、中毒机理 代谢功能、定量分析 -
 油漆、塑料、纤维、纺织品、橡胶、油脂、尘土、助燃剂比对等等...
油漆、塑料、纤维、纺织品、橡胶、油脂、尘土、助燃剂比对等等... -
 图像清晰化、声纹鉴定、音像认定、剪辑鉴定、模拟复原图像
图像清晰化、声纹鉴定、音像认定、剪辑鉴定、模拟复原图像 -
 硬盘数据恢复、密码破解、手机短信恢复、电脑使用痕迹、聊天记录恢复
硬盘数据恢复、密码破解、手机短信恢复、电脑使用痕迹、聊天记录恢复